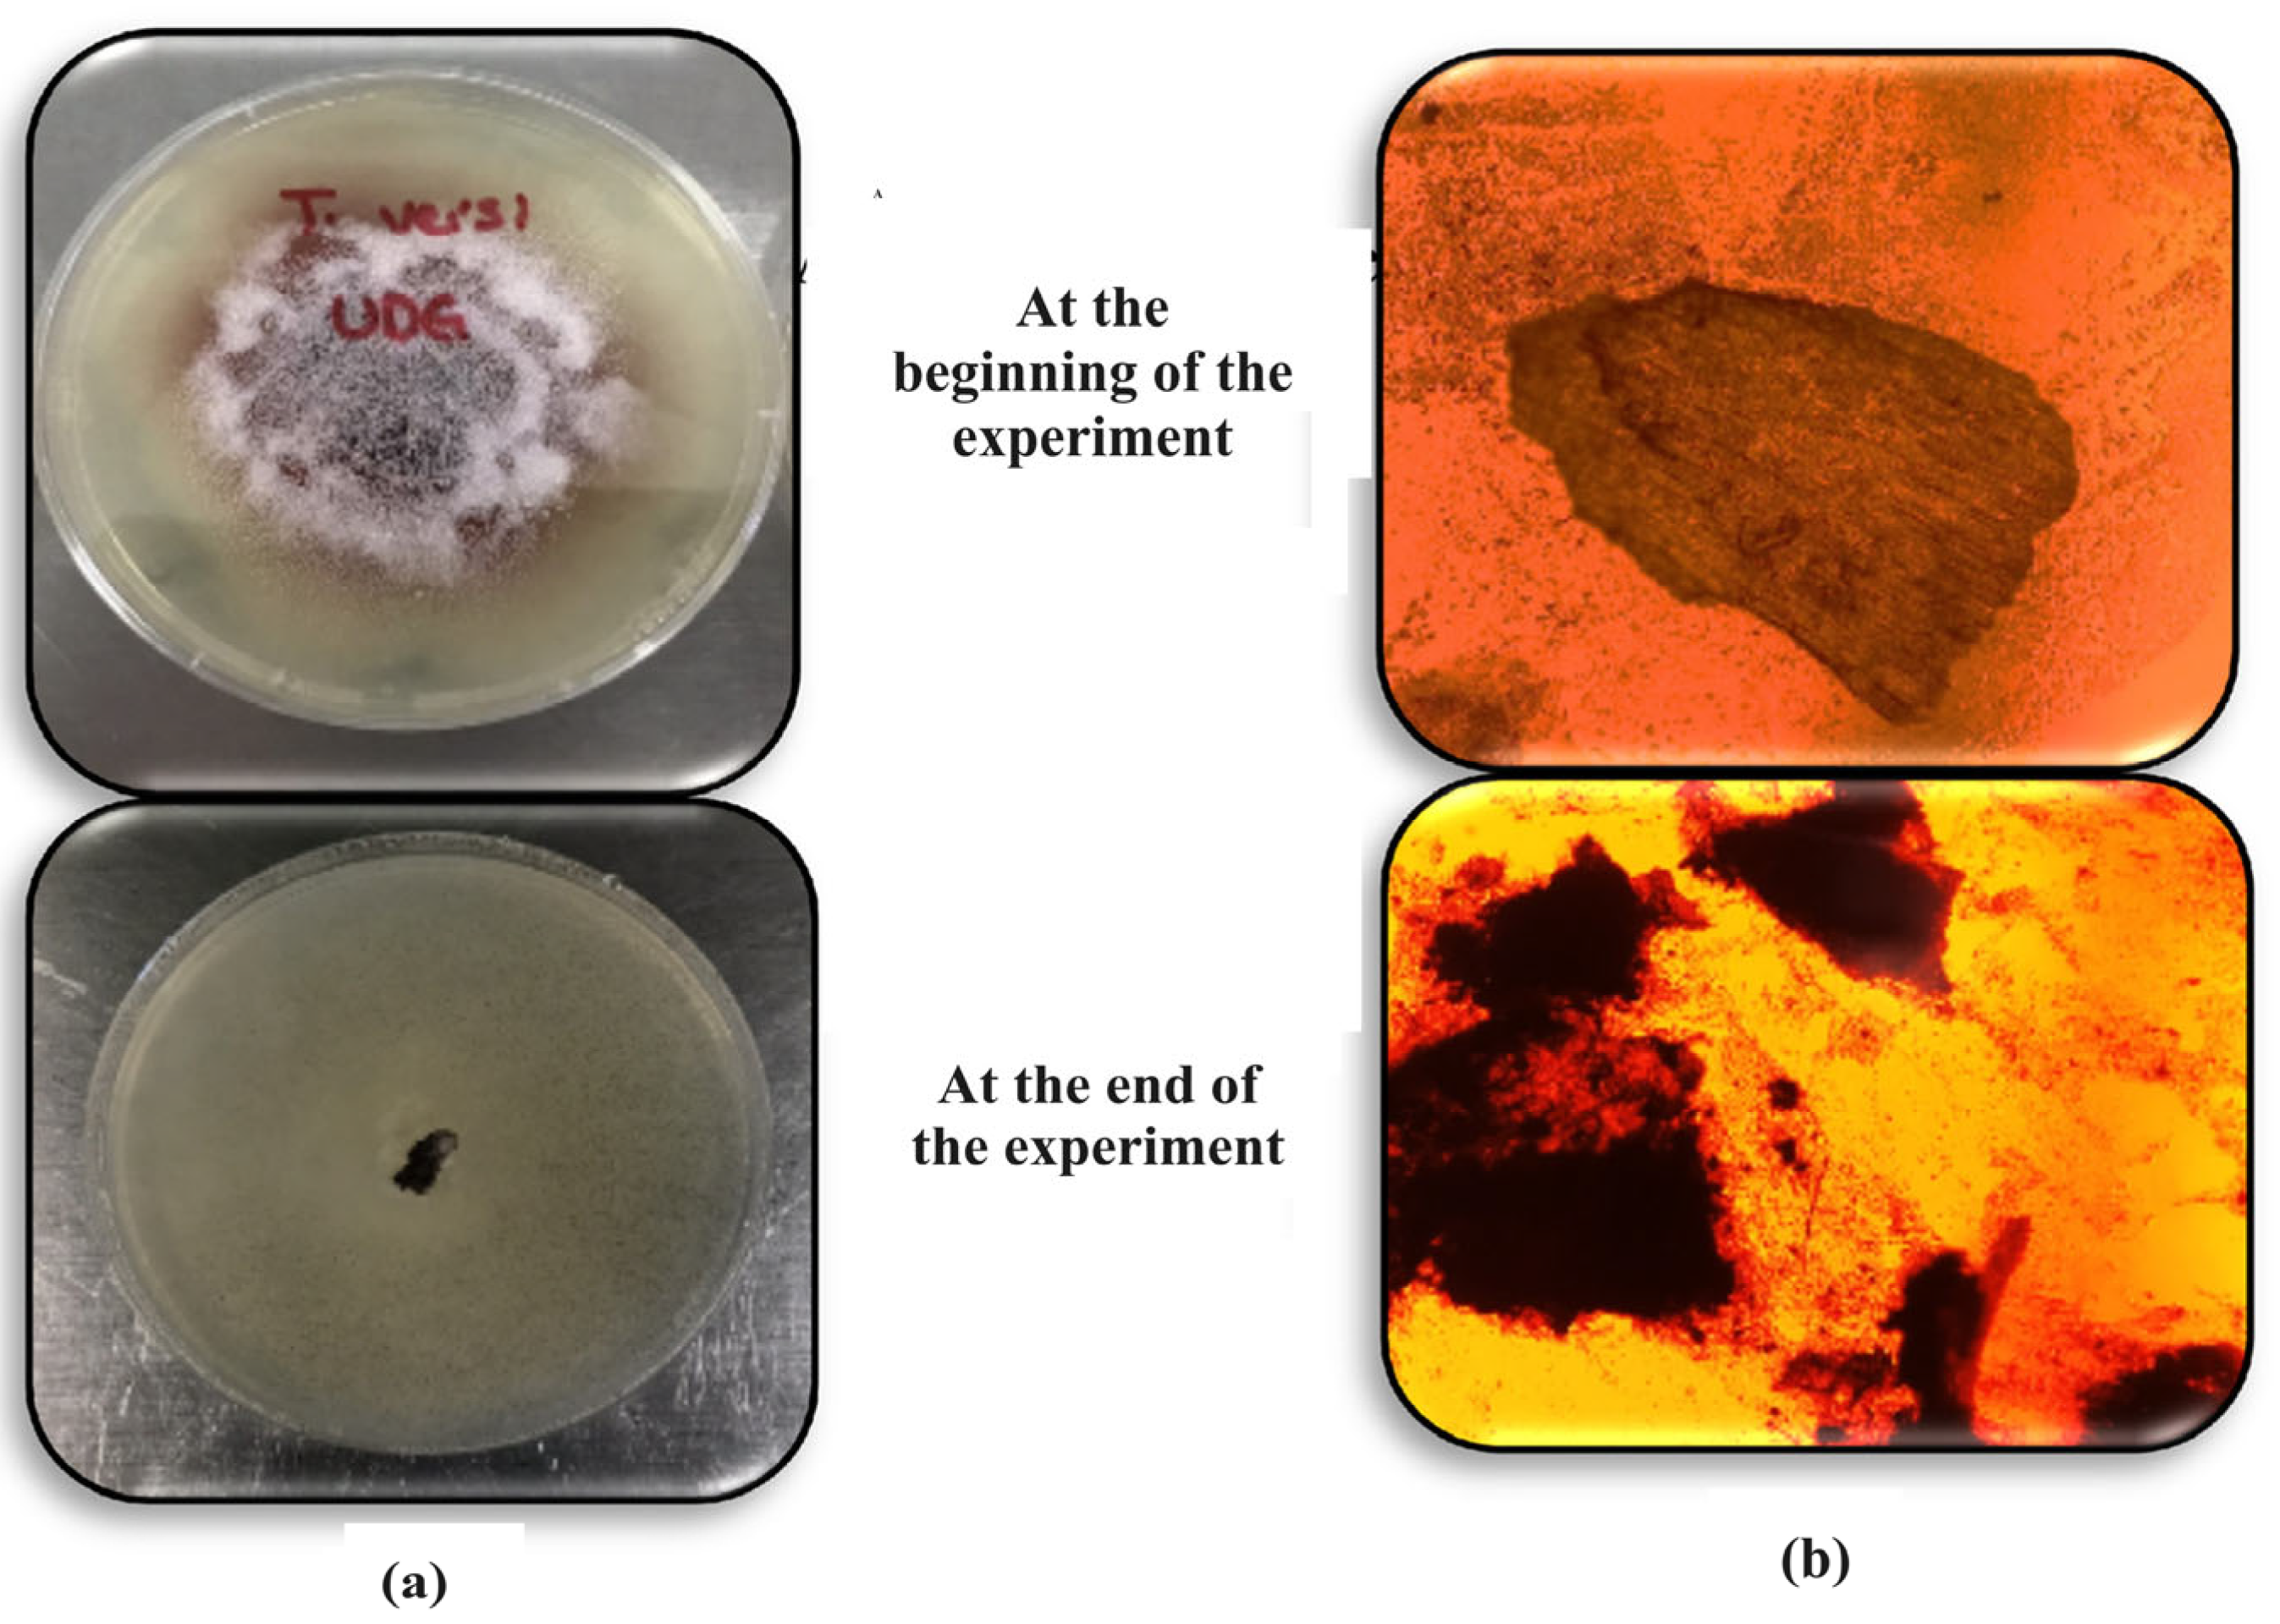
Water 16 01778 g004 Water 16 01778 g004

Tequila Vinasse Treatment in Two Types of Vertical Downflow Treatment Wetlands (with Emergent Vegetation and Ligninolytic Fungi)
Abstract
1. Introduction
2. Materials and Methods
2.1. Production and Immobilization of Trametes Versicolor
2.2. Experimental Setup
2.3. Evaluation of the Systems for the Treatment of TVs
2.3.1. System Monitoring
2.3.2. Statistical Analysis of Data
3. Results and Discussion
3.1. Behavior of Parameters Measured In Situ in the VDFWs
3.2. Viability Tests on the Trametes vesicolor Fungus Used in Vertical Wetlands
3.3. Efficiency of the Systems for the Treatment of TVs
3.3.1. Total Suspended Solids and Total Dissolved Solids
3.3.2. Apparent Color, Turbidity and True Color
3.3.3. Organic Matter (COD, BOD5 and TOC)
3.3.4. Total Phosphorus
3.3.5. Total Nitrogen
3.3.6. Fats and Oils
4. Conclusions
Author Contributions
Funding
Data Availability Statement
Acknowledgments
Conflicts of Interest
References
- Consejo Regulador del Tequila (CRT). Available online: https://www.crt.org.mx/EstadisticasCRTweb/ (accessed on 3 February 2021).
- Montoya, A.; Tejeda, A.; Sulbarán-Rangel, B.C.; Zurita, F. Treatment of tequila vinasse mixed with domestic wastewater in two types of constructed wetlands. Water Sci. Technol. 2023, 87, 3072–3082. [Google Scholar] [CrossRef] [PubMed]
- Díaz-Vázquez, D.; Carrillo-Nieves, D.; Orozco-Nunnelly, D.A.; Senés-Guerrero, C.; Gradilla-Hernández, M.S. An integrated approach for the Assessment of Environmental Sustainability in Agro-Industrial Waste Management Practices. Front. Environ. Sci. 2021, 9, 682093. [Google Scholar] [CrossRef]
- Zurita, F.; Tejeda, A.; Montoya, A.; Carrillo, I.; Sulbarán-Rangel, B.C.; Carreón-Álvarez, A. Generation of Tequila Vinasses, Characterization, Current Disposal Practices and Study Cases of Disposal Methods. Water 2022, 14, 1395. [Google Scholar] [CrossRef]
- Stefanakis, A.; Akratos, C.S.; Tsihrintzis, V.A. Constructed Wetlands, Eco-Engineering Systems for Wastewater and Sludge Treatment, 1st ed.; Reino Unido; Elsevier: Amsterdam, The Netherlands, 2014. [Google Scholar]
- Tejeda, A.; Valencia-Botín, J.A.; Zurita, F. Resistance evaluation of Canna indica, Cyperus papyrus, Iris sibirica, and Typha latifolia to phytotoxic characteristics of diluted tequila vinasses in wetland microcosms. Int. J. Phytoremediation 2022, 25, 1259–1268. [Google Scholar] [CrossRef] [PubMed]
- Garzón-Zúñiga, M.A.; Alvillo-Rivera, J.A.; Ramírez-Camperos, E.; Balbuena, G.; Díaz-Godínez, G.; Estrada-Arriaga, E.B. Evaluation of Ficus benjamina wood chip-based fungal biofiltration for the treatment of Tequila vinasses. Water Sci. Technol. 2018, 77, 1449–1459. [Google Scholar]
- Retes-Pruneda, J.L.; Dávila-Vázquez, G.; Medina-Ramírez, I.; Chávez-Vela, N.A.; Lozano-Álvarez, J.A.; Alatriste-Mondragón, F.; Jauregui-Rincón, J. High removal of chemical and biochemical oxygen demand from tequila vinasses by using physicochemical and biological methods. Environ. Technol. 2014, 35, 1773–1784. [Google Scholar] [CrossRef] [PubMed]
- Ramírez-Ramírez, A.; Sulbarán-Rangel, B.C.; Jáuregui-Rincón, J.; Lozano-Álvarez, J.A.; Flores-de la Torre, J.A.; Zurita-Martínez, F. Preliminary evaluation of three species of ligninolytic fungi for their possible incorporation in Vertical Flow Treatment Wetlands for the treatment of Tequila vinasse. Water Air Soil Pollut. 2021, 232, 5–16. [Google Scholar] [CrossRef]
- Pickard, M.A.; Roman, R.; Tinoco, R.; Vázquez-Duhalt, R. Polycyclic Aromatic Hydrocarbon Metabolism by White Rot Fungi and Oxidation by Coriolopsis gallica UAMH 8260 Laccase. Appl. Environ. Microbiol. 1999, 65, 3805–3809. [Google Scholar] [CrossRef]
- Trein, C.M.; García-Zumalacarregui, J.A.; de Andrade-Moraes, M.A.; Von-Sperling, M. Performance of a French system of vertical flow wetlands (first stage) operating with an extended feeding cycle. Water Sci. Technol. 2019, 80, 1443–1455. [Google Scholar] [CrossRef]
- APHA; AWWA; WEF. Standard Methods for the Examination of Water and Wastewater; American Public Health Association; American Water Works Association; Water Environment Federation: Washington, DC, USA, 2012. [Google Scholar]
- Dufresne, K.; Neculita, C.; Brisson, J.; Genty, T. Metal retention mechanisms in Pilot-Scale Constructed Wetlands receiving acid mine drainage. In Proceedings of the 10 International Conference on Acid Rock Drainage & IMWA Annual Conference, Santiago, Chile, 21–24 April 2015; pp. 1–6. [Google Scholar]
- López-López, A.; Contreras-Ramos, S.M. Tratamiento de Efluentes y Aprovechamiento de Residuos. In Ciencia y Tecnología del Tequila: Avancesy Perspectivas, 2nd ed.; Gschaedler-Mathis, A.C., Rodríguez-Garay, B., Prado-Ramírez, R., Flores-Montaño, J.L., Eds.; Logiprint Digital, S. DE R.L. DE C.V.®: Guadalajara, Mexico, 2015; p. 404. [Google Scholar]
- Songliu, L.; Hongying, H.; Yingxue, S.; Jia, Y. Effect of carbon source on the denitrification in constructed wetlands. J. Environ. Sci. 2009, 21, 1036–1043. [Google Scholar]
- Bian, Y.; Jin, X.; Feng, S.; Song, Z.; Shao, L. Study on the characteristics of natural zeolites in treating nitrogenous fertilizer industry wastewater. Hebei J. Ind. Sci. Technol. 2017, 31, 51–56. [Google Scholar]
- Wang, H.; Sun, J.; Xu, J.; Sheng, L. Study on clogging mechanisms of constructed wetlands from the perspective of wastewater electrical conductivity change under different substrate conditios. J. Envitonmental Manag. 2021, 292, 112813. [Google Scholar] [CrossRef] [PubMed]
- Che, J.; Yamaji, N.; Feng Ma, J. Efficient and flexible uptake system for mineral elements in plants. New Phytol. 2018, 219, 513–517. [Google Scholar] [CrossRef] [PubMed]
- Ravimannan, N.; Arulanantham, R.; Pathmanathan, S.; Niranjan, K. Alternative culture media for fungal growth using different formulation of protein sources. Sch. Res. Libr. 2014, 5, 36–39. [Google Scholar]
- Abdelhakeem, S.G.; Aboulroos, S.A.; Kamel, M.M. Performance of a vertical subsurface flow constructed wetland under different operational conditions. J. Adv. Res. 2016, 7, 803–814. [Google Scholar] [CrossRef]
- López-López, A.; Dávila-Vázquez, G.; León-Becerril, E.; Villegas-García, E.; Gallardo-Valdez, J. Tequila vinasses: Generation and full scale treatment processes. Environ. Sci. Biotechnol. 2010, 9, 109–116. [Google Scholar] [CrossRef]
- Yadav, A.; Chazarenc, F.; Mutnuri, S. Development of the French system vertical flow constructed wetland to treat raw domestic watewater in India. Ecol. Eng. 2018, 113, 88–93. [Google Scholar] [CrossRef]
- Martínez, M.; Osorio, A. Validación de un método para el análisis de color real en agua. Rev. Fac. Cienc. 2018, 7, 143–155. [Google Scholar]
- Kubínova, T.; Kyncl, M. Comparison of standard methods for determining the color of water in several countries. In IOP Conference Series: Earth and Environmental Science; IOP Publishing: Bristol, UK, 2021; pp. 12–18. [Google Scholar]
- Cea-Barcia, G.E.; Imperial-Cervantes, R.A.; Torres-Zuniga, I.; Van Den Hende, S. Converting tequila vinasse diluted with tequila process water into microalgae-yeast flocs and dischargeable effluent. Bioresour. Technol. 2020, 300, 122644. [Google Scholar] [CrossRef] [PubMed]
- Ahmed, P.M.; de Figueroa, L.I.C.; Pajot, H.F. Dual Purpose of ligninolytic- basidiomycetes: Mycoremediation of bioethanol distillation vinasse coupled to sustainable bio-based compounds production. Fungal Biol. Rev. 2019, 34, 25–40. [Google Scholar] [CrossRef]
- dos Reis, K.C.; Arrizon, J.; Amaya-Delgado, L.; Gschaedler, A.; Freitas-Schwan, R.; Ferreira-Silva, C. Volatile compounds flavoring obtained from Brazilian and Mexican spirit wastes by yeasts. World J. Microbiol. Biotechnol. 2018, 34, 152. [Google Scholar] [CrossRef] [PubMed]
- Potentini, M.F.; Rodríguez-Malaver, J. Vinasse biodegradation by Phanerochaete chrysosporium. J. Environ. Biol. 2006, 27, 661–665. [Google Scholar] [PubMed]
- Teymennet-Ramírez, K.; García-Morales, S.; Hernández-Fernández, O.; Barrera Martínez, I. Detoxification of tequila vinasse by Trametes sanguineus: A biotechnological approach to lacasse production and water reuse in seedling growth. Res. Sq. 2023, 1–19. [Google Scholar] [CrossRef]
- Robles-González, V.; Galíndez-Mayer, J.; Rinderknecht-Seijas, N.; Poggi-Varaldo, H.M. Treatment of mezcal vinasses: A review. J. Biotechnol. 2012, 157, 524–546. [Google Scholar] [CrossRef] [PubMed]
- Johnson, I.; Sithik-Ali, M.A.; Kumar, M. Cyanobacteria/Microalgae for distillery wastewater treatment-past, present and the future. In Microbial Wastewater Treatment; Shah, M.P., Rodríguez-Couto, S., Eds.; Elsevier: Amsterdam, The Netherlands, 2019; p. 258. [Google Scholar]
- Vilar, D.S.; Carvalho, G.O.; Pupo, M.M.S.; Aguiar, M.M.; Torres, N.H.; Américo, J.H.P.; Cavalcanti, E.B.; Eguiluz, K.I.B.; Salazar-Banda, G.R.; Leite, M.S.; et al. Vinasse degradation using Pleurotus sajor-caju in a combined biological—Electrochemical oxidation treatment. Sep. Purif. Technol. 2018, 192, 287–296. [Google Scholar] [CrossRef]
- Alves-Junior, J.; Araujo-Vieira, Y.; Andrade-Cruz, I.; Silva-Vilar, D.; Aguiar, M.M.; Hortense-Torres, N.; Naresh-Bharagava, R.; Silva-Lima, A.; Lucena-de Souza, R.; Romanholo-Ferreira, L.F. Sequential degradation of raw vinasse by a laccase enzyme producing fungus Pleurotus sajor-caju and its ATPS purification. Biotechnol. Rep. 2020, 25, e00411. [Google Scholar]
- Melamane, X.L.; Strong, P.J.; Burgess, J.E. Treatment of wine distillery wastewater: A review with emphasis on anaerobic membrane reactors. S. Afr. J. Enol. Vitic. 2007, 28, 25–36. [Google Scholar] [CrossRef]
- Vadivel, R.; Singh-Minhas, P.; Kumar, S.; Singh, Y.; Rao, N.; Nirmale, A. Significance of vinasses waste management in agriculture and environmental quality—Review. African J. Agric. Res. 2014, 9, 2862–2873. [Google Scholar]
- Chandra, R.; Bharagava, R.N.; Kapley, A.; Purohit, H.J. Characterization of Phragmites cummunis rhizosphere bacterial communities and metabolic products during the two stage sequential treatment of post methanated distillery effluent by bacteria and wetland plants. Bioresour. Technol. 2012, 103, 78–86. [Google Scholar] [CrossRef] [PubMed]
- Chowdhary, P.; Yadav, A.; Kaithwas, G.; Bharagava, R.N. Distillery wastewater: A major source of environmental pollution and its biological treatment for environmental safety. In Green Technologies and Environmental Sustainability; Singh, R., Kumar, S., Eds.; Springer: Cham, Switzerland, 2017; pp. 409–435. [Google Scholar]
- España-Gamboa, E.; Chablé-Villacis, R.; Alzate-Gaviria, L.; Domínguez-Maldonado, J.; Leal-Bautista, R.M.; Soberanis-Monforte, G.; Tapia-Tussell, R. Native fungal strains from Yucatan, an option for treatment of biomethanated vinase. Rev. Mex. Ing. Química 2021, 20, 607–620. [Google Scholar] [CrossRef]
- Aparecida-Christofoletti, C.; Escher, J.P.; Evangelista-Correia, J.; Urbano-Marinho, J.F.; Fontanetti, C.S. Sugarcane vinasse: Environmental implications of its use. Waste Manag. 2013, 33, 2752–2761. [Google Scholar] [CrossRef] [PubMed]
- Moran-Salazar, R.G.; Sanchez-Lizarraga, A.L.; Rodriguez-Campos, J.; Davila-Vazquez, G.; Marino-Marmolejo, E.N.; Dendooven, L.; Contreras-Ramos, S. M R. Utilization of vinasses as soil amendment: Consequences and perspectives. SpringerPlus 2016, 5, 1007. [Google Scholar] [CrossRef] [PubMed]
- Rehman, F.; Pervez, A.; Khattak, B.N.; Ahmad, R. Constructed wetlands: Perspectives of the oxygen released in the Rhizosphere of Macrophytes. Clean Soil Air Water 2017, 45, 1–9. [Google Scholar] [CrossRef]
- Alves-Sánchez, A.; Ferreira, A.C.; Martins-Stopa, J.; Cardoso-Bellato, F.; Araújo de Jesús, T.; Gomes-Coelho, L.H.; Domingues, M.R.; Subtil, E.L.; Matheus, D.R.; Frederigi-Benassi, R. Organic matter, Turbidity, and apparent color removal in planted (Typha sp. and Eleocharis sp.) and unplanted constructed wetlands. J. Environ. Eng. 2018, 144, 06018007. [Google Scholar] [CrossRef]
- Arun-Kumar, M.; Sheik-Abdullah, S.; Sampath-Kumar, P.; Dheeba, B.; Mathumitha, C. Comparative study on potentiality of bacteria and fungi in bioremediation and decolorization of molasses spent wash. J. Pure Appl. Microbiol. 2008, 2, 393–400. [Google Scholar]
- Ferreira, L.F.; Aguiar, M.M.; Messias, T.G.; Pompeu, G.; Lopez, A.M.Q.; Silva, D.P.; Monteiro, R.T. Evaluation of sugar-cane vinasse treated with Pleurotus sajor-caju utilizing aquatic organisms as toxicological indicators. Ecotoxicol. Environ. Saf. 2011, 74, 132–137. [Google Scholar] [CrossRef] [PubMed]
- Prigent, S.; Belbeze, G.; Paing, J.; Andres, Y.; Voisin, J.; Chazarenc, F. Biological characterization and tretament performances of a compact vertical flow constructed wetland with the use of expanded schist. Ecol. Eng. 2013, 52, 12–18. [Google Scholar] [CrossRef]
- Arévalo-Durazno, M.B.; García-Zumalacarregui, J.A.; Ho, L.; Narváez, A.; Alvarado, A. Performance of modified first-stage French Vertical Flow Constructed Wetlands under extreme operational conditions. Water Sci. Technol. 2023, 88, 220. [Google Scholar] [CrossRef]
- Va, V.; Soleh-Setiyawan, A.; Soewondo, P.; Wulandari-Putri, D. The characteristics of domestic wastewater from office buildings in Bandung, West Java, Indonesia. Indones. J. Urban Environ. Technol. 2018, 1, 199–214. [Google Scholar] [CrossRef][Green Version]
- Ferreira-dos Santos, J.; Vieira-Canettieri, E.; Souza, S.M.; Rodrigues, R.C.L.B.; Acosta-Martínez, E. Treatment of sugarcane vinasse from cachaca production for the obtainment of Candida utilis CCT 3469 biomass. Biochem. Eng. J. 2019, 148, 131–137. [Google Scholar] [CrossRef]
- Siles, J.A.; El Bari, H.; Ibn Ahmed, S.; Chica, A.F.; Martín, M.A. Pretreatment: The Key Issue in Vinasse Valorization. Pre-Processing of Manure and Organic Waste for Energy Production RAMIRAN 2010. pp. 12–15. Available online: http://ramiran.uvlf.sk/ramiran2010/docs/Ramiran2010_0060_final.pdf (accessed on 3 March 2024).
- Ferrazzo-Naspolini, B.; de Oliveira-Machado, A.C.; Cravo-Junior, W.B.; Guimaraes-Freire, D.M.; Christe-Cammarota, M. Bioconversion of sugarcane vinasse into High-Added Value Products and Energy. Biomed. Res. Int. 2017, 2017, 8986165. [Google Scholar]
- Xu, Q.; Cui, L. Removal of COD from synthetic wastewater in vertical flow constructed wetland. Water Environ. Res. 2019, 91, 1661–1668. [Google Scholar] [CrossRef]
- Maucieri, C.; Salvato, M.; Borin, M. Vegetation contribution on phosphorus removal in constructed wetlands. Ecol. Eng. 2020, 152, 105853. [Google Scholar] [CrossRef]
- Zapater-Pereyra, M.; Malloci, E.; van Bruggen, J.J.A.; Lens, P.N.L. Use of marine and engineered materials for the removal of phosphorous from secondary effluent. Ecol. Eng. 2014, 73, 635–642. [Google Scholar] [CrossRef]
- Kit-Tang, J.; Hazwan-Jusoh, M.N.; Jusoh, H. Nitrogen and phosphorous removal of wastewater via constructed wetlands approach. Trop. Aquat. Soil Pollut. 2023, 3, 76–87. [Google Scholar] [CrossRef]
- Lai, D.Y. Phosphorous fractions and fluxes in the solis of a free surface flow constructed wetland in Hong Kong. Ecol. Eng. 2014, 73, 73–79. [Google Scholar] [CrossRef]
- Wang, X.; Zheng, Y.; Gao, Y.; Zhou, Q.; Liu, M.; Li, H. Phosphorous removal in constructed wetlands: A review on research progress and limitation. Sci. Total Environ. 2018, 631–632, 1182–1194. [Google Scholar]
- Penn, C.J.; Bryant, R.B.; Kleinman, P.J.A.; Allen, A.L. Removing dissolved phosphorus from drainage ditch water with phosphorus sorbing materials. J. Soil Water Conserv. 2007, 62, 269–276. [Google Scholar]
- Lyngsie, G.; Borggaard, O.K.; Hansen, H.C.B. A three-step test of phosphate sorption efficiency of potential agricultural drainage filter materials. Water Res. 2017, 51, 256–265. [Google Scholar] [CrossRef]
- Pugliese, L.; Canga, E.; Hansen, H.C.B.; Kjaergaard, C.; Heckrath, J.; Poulsen, T.G. Long-term phosphorus removal by Ca and Fe-rich drainage filter materials under variable flow and inlet concentrations. Water Res. 2023, 247, 120792. [Google Scholar] [CrossRef]
- Mendes, L.R.D.; Pugliese, L.; Canga, E.; Wu, S.; Heckrath, J. Analysis of reactive phosphorus treatment by filter materials at the edge of tile-drained agricultural catchments: A global view of the current status and challenges. J. Environ. Manag. 2022, 324, 116329. [Google Scholar] [CrossRef]
- Gustafsson, J.P.; Renman, A.; Renman, G.; Poll, K. Phosphate removal by mineral- based sorbents used in filters for small-scale wastewater treatment. Water Res. 2008, 42, 189–197. [Google Scholar] [CrossRef] [PubMed]
- Klimeski, A.; Chardon, W.J.; Turtola, E.; Uusitalo, R. Potential and limitations of phosphate retention media in water protection: A process-based review of laboratory and field-scale tests. Agric. Food Sci. 2012, 21, 206–223. [Google Scholar] [CrossRef]
- Vohla, C.; Koiv, M.; Bavor, H.J.; Chazarenc, F.; Mander, U. Filter materials for phosphorous removal from wastewater in treatment wetlands–A review. Ecol. Eng. 2011, 37, 70–89. [Google Scholar] [CrossRef]
- Li, F.; Lu, L.; Zheng, X.; Ngo, H.H.; Liang, S.; Guo, W. Enhanced nitrogen removal in constructed wetlands: Effects of dissolved oxygen and stept-feeding. Bioresour. Technol. 2014, 169, 395–402. [Google Scholar] [CrossRef] [PubMed]
- Martínez, N.B.; Tejeda, A.; Del Toro, A.; Sánchez, M.P.; Zurita, F. Nitrogen removal in pilot-scale partially saturated vertical wetlands with and without an internal spurce of carbon. Sci. Total Environ. 2018, 645, 524–532. [Google Scholar] [CrossRef] [PubMed]
- Del Toro, A.; Tejeda, A.; Zurita, F. Addition of Corn Cob in the Free Drainage Zone of Partially Saturated Vertical Wetlands Planted with I. sibirica for Total Nitrogen Removal—A Pilot-Scale Study. Water. 2019, 11, 2151. [Google Scholar] [CrossRef]
- Langergraber, G.; Prandtstetten, C.; Pressl, A.; Sleytr, K.; Leroch, K.; Rohrhofer, R.; Al, E. Wastewater Treatment, Plant Dynamics and Management in Constructed and Natural Wetlands. In Wastewater Treatment, Plant Dynamics and Management in Constructed and Natural Wetlands; Vymazal, J., Ed.; Springer: Dordrecht, The Netherlands, 2008; pp. 199–209. [Google Scholar]
- Masi, F.; Martinuzzi, N. Constructed wetlands for the Mediterranean countries: Hybrid systems for water reuse and sustainable sanitation. Desalination 2007, 215, 44–55. [Google Scholar] [CrossRef]
- Del Toro-Farías, A.; Zurita-Martínez, F. Changes in the nitrification-denitrification capacity of pilot-scale partially saturated vertical flow wetlands (with conrcob in the free-drainage zone) after two years of operation. Int. J. Phytoremediation 2021, 23, 829–836. [Google Scholar] [CrossRef] [PubMed]
- Saeed, T.; Sun, G. A review on nitrogen and organics removal mechanisms in subsurface flow constructed wetlands: Dependency on environmental parameters, operating conditions and supporting media. J. Environ. Manag. 2012, 112, 429–448. [Google Scholar] [CrossRef]
- Romillac, N. Ammonification. In Encyclopedia of Ecology, 2nd ed.; Elsevier: Amsterdam, The Netherlands, 2019; pp. 256–263. [Google Scholar]
- Kadlec, R.H.; Wallace, S.D. Treatment Wetlands, 2nd ed.; CRC Press: Boca Raton, FL, USA, 2009. [Google Scholar]
- Muwafaq-Hussein, M.A. Mechanistic Understanding of Ammonia Removal Kinetics in Floating Treatment Wetlands. Ph.D. Thesis, University of Leicester, Leicester, UK, 2019. [Google Scholar]
- Stefanakis, A.I.; Prigent, S.; Breuer, R. Integrated Produced Water Management in a Desert Oilfield Using Wetland Technology and Innovative Reuse Practices. In Constructed Wetlands for Industrial Wastewater Treatment; Stefanakis, A.I., Ed.; John Wiley & Sons Ltd.: Oxford, UK, 2018; p. 586. [Google Scholar]

| Removal Percentage | ||||
|---|---|---|---|---|
| Influent Concentrations | VDFW-LF | VDFW with Vegetation | Control VDFW | |
| TSS (mgL−1) | 781 ± 401 | 20 | 36 a | 16 |
| TDS (mgL−1) | 28,716 ± 4626 | 32 | 39 | 34 |
| Apparent color (Pt-Co) | 15,430 ± 2698 | 25 | 36 a | 24 |
| Turbidity (NTU) | 500.36 ± 197.61 | 32 | 46 a | 27 |
| True color (Pt-Co) | 6400 ± 1417 | 17 | 21 | 21 |
| COD (mgL−1) | 49,423 ± 12,933 | 35 | 40 | 35 |
| DBO5 (mgL−1) | 22,855 ± 5578 | 35 | 43 | 35 |
| TOC (mgL−1) | 16,032 ± 9151 | 43 | 55 | 44 |
| Total phosphorus (mgL−1) | 678 ± 826 | 11 | 11 | 10 |
| Total nitrogen (mgL−1) | 306.94 ± 59.79 | 26 | 36 | 26 |
| Fats and oils (mgL−1) | 0.27 ± 0.13 | 42 | 46 | 38 |
Disclaimer/Publisher’s Note: The statements, opinions and data contained in all publications are solely those of the individual author(s) and contributor(s) and not of MDPI and/or the editor(s). MDPI and/or the editor(s) disclaim responsibility for any injury to people or property resulting from any ideas, methods, instructions or products referred to in the content. |
© 2024 by the authors. Licensee MDPI, Basel, Switzerland. This article is an open access article distributed under the terms and conditions of the Creative Commons Attribution (CC BY) license (https://creativecommons.org/licenses/by/4.0/).
Share and Cite
Ramírez-Ramírez, A.A.; Lozano-Álvarez, J.A.; Gutiérrez-Lomelí, M.; Zurita, F. Tequila Vinasse Treatment in Two Types of Vertical Downflow Treatment Wetlands (with Emergent Vegetation and Ligninolytic Fungi). Water 2024, 16, 1778. https://doi.org/10.3390/w16131778
Ramírez-Ramírez AA, Lozano-Álvarez JA, Gutiérrez-Lomelí M, Zurita F. Tequila Vinasse Treatment in Two Types of Vertical Downflow Treatment Wetlands (with Emergent Vegetation and Ligninolytic Fungi). Water. 2024; 16(13):1778. https://doi.org/10.3390/w16131778
Chicago/Turabian StyleRamírez-Ramírez, Anderson A., Juan A. Lozano-Álvarez, Melesio Gutiérrez-Lomelí, and Florentina Zurita. 2024. "Tequila Vinasse Treatment in Two Types of Vertical Downflow Treatment Wetlands (with Emergent Vegetation and Ligninolytic Fungi)" Water 16, no. 13: 1778. https://doi.org/10.3390/w16131778
APA StyleRamírez-Ramírez, A. A., Lozano-Álvarez, J. A., Gutiérrez-Lomelí, M., & Zurita, F. (2024). Tequila Vinasse Treatment in Two Types of Vertical Downflow Treatment Wetlands (with Emergent Vegetation and Ligninolytic Fungi). Water, 16(13), 1778. https://doi.org/10.3390/w16131778

